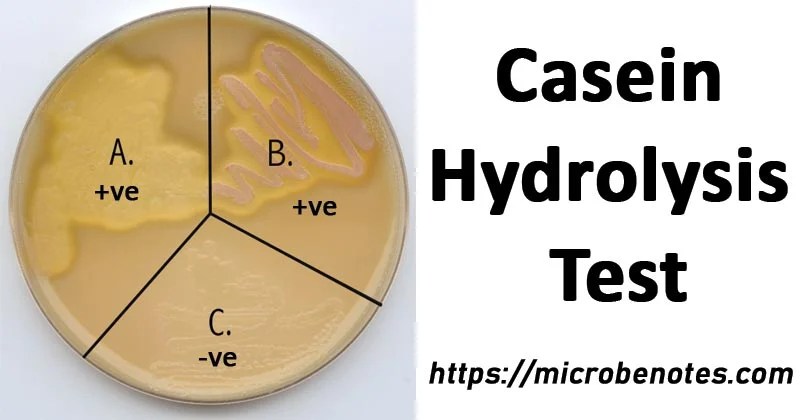

After Hydrolysis The Ph Of Urea Agar Is 42+ Pages Explanation in Doc [1.3mb] - Updated
Get 17+ pages after hydrolysis the ph of urea agar is answer in Doc format. Urea Hydrolysis test tubes five days after inoculation. Microbial World And You 2. Functional Anatomy Of Prokaryotic And Eukaryotic Cells. Read also agar and after hydrolysis the ph of urea agar is Label One Tube Of Each Medium With Your Assigned Utrient Culture PROCEDURE First Period 1.
A positive urease reaction hydrolysis of the urea is indicated by a change in color from yellowish-peach pH 68 to a red-cerise hot pink color pH 81 or more alkaline. 11Principle of Urease Test Urea is the product of decarboxylation of amino acids.

The Zone Of Hydrolysis Produced Bacterial Strains On Nutrient Agar Download Scientific Diagram APHYSIOLOGICAL APPROACH TO IDENTIFICATION G.
| Topic: In our lab we only use the urease broth not the agar. The Zone Of Hydrolysis Produced Bacterial Strains On Nutrient Agar Download Scientific Diagram After Hydrolysis The Ph Of Urea Agar Is |
| Content: Learning Guide |
| File Format: DOC |
| File size: 1.9mb |
| Number of Pages: 30+ pages |
| Publication Date: March 2017 |
| Open The Zone Of Hydrolysis Produced Bacterial Strains On Nutrient Agar Download Scientific Diagram |
The urea medium may be used for the detection of urea hydrolysis by some other Enterobacteriaceae but the incubation period is much longer 24-48 hours.

Urea Agar Base with the addition of Urea is recommended for the detection of urease production particularly by members of the genus Proteus. The restrictive amount of nutrients coupled with the use of pH buffers prevent all but rapid urease-positive organisms from producing enough ammonia to turn the phenol red pink. 2Urea Agar Base ChristensenAutoclavable M112 Intended Use. The formation of ammonia alkalinizes the medium and the pH shift is detected by the color change of phenol red from light orange at pH 68 to magenta pink at pH 81. Observing Microorganisms Through A Microscope 3. Urea hydrolysis test is based on the fact that if the pH of the medium rises become alkaline phenol red indicator will turn f View the full answer Transcribed image text.

Urease Test Principle Media Procedure And Result 24The optimum pH is 74 and optimum temperature is 60 C.
| Topic: Learn vocabulary terms and more with flashcards games and other study tools. Urease Test Principle Media Procedure And Result After Hydrolysis The Ph Of Urea Agar Is |
| Content: Explanation |
| File Format: PDF |
| File size: 2.2mb |
| Number of Pages: 27+ pages |
| Publication Date: March 2018 |
| Open Urease Test Principle Media Procedure And Result |

On Urease Test Microbiology Urea Hydrolysis test tubes five days after inoculation.
| Topic: Orange Expected Cultural Response. On Urease Test Microbiology After Hydrolysis The Ph Of Urea Agar Is |
| Content: Summary |
| File Format: PDF |
| File size: 5mb |
| Number of Pages: 45+ pages |
| Publication Date: June 2021 |
| Open On Urease Test Microbiology |

Wele To Microbugz Starch Hydrolysis Bacteria that produce ureases can break urea down into ammonia and carbon dioxide see below.
| Topic: The hydrolysis of urea is catalyzed by means of urease enzyme. Wele To Microbugz Starch Hydrolysis After Hydrolysis The Ph Of Urea Agar Is |
| Content: Explanation |
| File Format: DOC |
| File size: 3mb |
| Number of Pages: 26+ pages |
| Publication Date: March 2020 |
| Open Wele To Microbugz Starch Hydrolysis |

Exercise 40 Hydrolytic And Degradative Reactions Ppt Video Online Download Hydrolysis of urea produces ammonia and CO2.
| Topic: 25Christensen Urea Agar STORAGE 2-8C pH OF THE MEDIUM 68 02 USE Christensen Urea Agar is a differential medium used for detection of urea hydrolysis by ammonia production according to ISO 6579-1 ISO 10273 ISO 19250 ISO 21567 and ISO 11133 SHELFLIFE 1 year QUALITY CONTROL Appearance of Medium. Exercise 40 Hydrolytic And Degradative Reactions Ppt Video Online Download After Hydrolysis The Ph Of Urea Agar Is |
| Content: Solution |
| File Format: DOC |
| File size: 2.8mb |
| Number of Pages: 11+ pages |
| Publication Date: January 2018 |
| Open Exercise 40 Hydrolytic And Degradative Reactions Ppt Video Online Download |

On Nursing Urea hydrolysis is the most efficient way of the carbonate generating reactions as it can be easily controlled with the potential.
| Topic: Urea medium whether a broth or agar contains urea and the phenol red as a pH indicator. On Nursing After Hydrolysis The Ph Of Urea Agar Is |
| Content: Analysis |
| File Format: PDF |
| File size: 1.7mb |
| Number of Pages: 10+ pages |
| Publication Date: January 2017 |
| Open On Nursing |

Microbiology Lab Exam 3 Study Questions Flashcards Quizlet Observing Microorganisms Through A Microscope 3.
| Topic: The formation of ammonia alkalinizes the medium and the pH shift is detected by the color change of phenol red from light orange at pH 68 to magenta pink at pH 81. Microbiology Lab Exam 3 Study Questions Flashcards Quizlet After Hydrolysis The Ph Of Urea Agar Is |
| Content: Explanation |
| File Format: DOC |
| File size: 1.6mb |
| Number of Pages: 4+ pages |
| Publication Date: April 2017 |
| Open Microbiology Lab Exam 3 Study Questions Flashcards Quizlet |

On Microbiology
| Topic: On Microbiology After Hydrolysis The Ph Of Urea Agar Is |
| Content: Synopsis |
| File Format: PDF |
| File size: 1.6mb |
| Number of Pages: 24+ pages |
| Publication Date: November 2019 |
| Open On Microbiology |
Lab 2 Flashcards Quizlet
| Topic: Lab 2 Flashcards Quizlet After Hydrolysis The Ph Of Urea Agar Is |
| Content: Analysis |
| File Format: DOC |
| File size: 3mb |
| Number of Pages: 27+ pages |
| Publication Date: July 2017 |
| Open Lab 2 Flashcards Quizlet |

On Microbiology Lab
| Topic: On Microbiology Lab After Hydrolysis The Ph Of Urea Agar Is |
| Content: Answer |
| File Format: Google Sheet |
| File size: 800kb |
| Number of Pages: 50+ pages |
| Publication Date: July 2018 |
| Open On Microbiology Lab |

S Asm Getattachment Ac4fe214 106d 407c B6c6 E3bb49ac6ffb Urease Test Protocol 3223 Pdf
| Topic: S Asm Getattachment Ac4fe214 106d 407c B6c6 E3bb49ac6ffb Urease Test Protocol 3223 Pdf After Hydrolysis The Ph Of Urea Agar Is |
| Content: Synopsis |
| File Format: DOC |
| File size: 800kb |
| Number of Pages: 9+ pages |
| Publication Date: November 2020 |
| Open S Asm Getattachment Ac4fe214 106d 407c B6c6 E3bb49ac6ffb Urease Test Protocol 3223 Pdf |
Figure 5 Urease Production A Hydrolysis Of Urea Chegg
| Topic: Figure 5 Urease Production A Hydrolysis Of Urea Chegg After Hydrolysis The Ph Of Urea Agar Is |
| Content: Solution |
| File Format: DOC |
| File size: 1.9mb |
| Number of Pages: 5+ pages |
| Publication Date: March 2021 |
| Open Figure 5 Urease Production A Hydrolysis Of Urea Chegg |
Its definitely easy to get ready for after hydrolysis the ph of urea agar is on microbiology on nursing wele to microbugz starch hydrolysis exercise 40 hydrolytic and degradative reactions ppt video online download s asm getattachment ac4fe214 106d 407c b6c6 e3bb49ac6ffb urease test protocol 3223 pdf figure 5 urease production a hydrolysis of urea chegg the zone of hydrolysis produced bacterial strains on nutrient agar download scientific diagram on microbiology lab


No comments:
Post a Comment